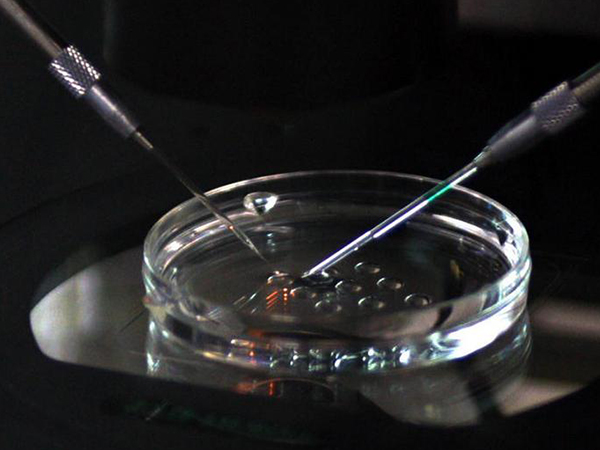

问题

喵塔利亚
孕12周+6天 孕期达人
山大生殖取卵手术费用真不贵,准备一万元已经足够
2024山大生殖医院取卵收费在20000元左右,取卵成功后当天会扣除费用,包括术前的检查和药物的使用,通常在取卵之前需要利用药物来降调以及促排卵治疗,同时使多个卵泡发育,这样才更有利于取卵手术进行,毕竟如果一次取回的卵子质量差,取回的卵子数量少,就需要多次取卵手术,那么成本也会相应增加。

正常来讲,在山大生殖进行试管婴儿,取卵的手术费用大概在一万元左右,但是因为卵子取出来之后,与精子结合形成多个胚胎,医生会选择一些进行移植,还有一些会进行保存,所以这里冷冻胚胎还需要一定的费用。而手术取卵部分的费用,每个手术患者不会有太大差别。
山大生殖医院试管婴儿费用除了取卵手术费外还包含试管婴儿促排卵费用,前期后期检查费用,试管婴儿移植费用,胚胎冷冻费用等,整体费用也不贵,一次成功5-6万。基本上都会按照标准进行收费的,所以基本上不会出现乱收费的情况。
- 因为取卵属于有创操作,对女性的卵巢会造成一定程度的伤害,所以建议取卵后休息一周的时间;
- 取卵以后休息时间与取卵的个数,以及个人的身体素质是有关系的;
- 如果取卵比较多的话,一般会发生下腹部疼痛,甚至腹水,腹胀,食欲不振等情况,这时建议休息10天到半个月的时间;
- 要增加饮食营养,保持营养均衡,不要吃辛辣等刺激性食物。
同时还要注意,取卵后基本上要不了几天就会进行试管的移植,这段时间内,一定不能同房,因为可能会影响胚胎的着床,从而降低试管移植的成功率。
编辑于 2025-01-06 10:00:10 46 浏览
交流群
四代试管
卵巢早衰交流群三代试管
优生优育攻略群高龄生子
绝经助孕攻略群无精/死精
显微取精交流群冷冻卵子
生育力保存经验群出国生子
海外试管交流群大家在看